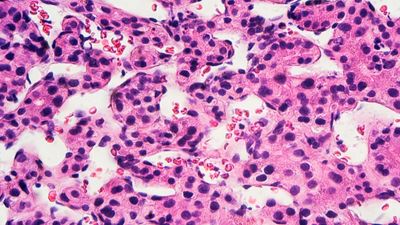

My name is Kayla Torres, a rising Junior at CSI High School and with the help of the DREAM High program I was able to accomplish so much in a short span of time. I've been inspired to pursue a career path in Pathology or Forensic Pathology.
Through hands-on programming, DREAM-High Scholars visualize and analyze genomics, clinical, and physical data from breast cancer cells. DREAM-High is a partnership between the Columbia Center for Cancer Systems Therapeutics, the Palazzo Strozzi Foundation USA, the Stanford Center for Cancer Systems Biology, and the Institute for Systems Biology.
In the DREAM-High program, Scholars learn to program in R, a language for statistical computing and graphics. They manipulate and write code in a cloud-based RStudio environment to analyze a wide range of data on breast cancer patients and cancer cell lines.
I created heat maps as colorized representations of data matrices. I reordered features and observations so that similar entities are close to each other in the graph. Heat maps make it easy to visualize and understand complex data.
I loaded and examined a data frame of clinical information from 1,082 breast cancer patients from The Cancer Genome Atlas (TCGA). I summarized clinical measurements on both the patients, such as gender and age, and the patients’ tumors, such as estrogen receptor status and histology.
I performed an integrative analysis of clinical measurements and gene expression data for 1,082 patients in the TCGA Breast Cancer cohort. By calculating heat maps and annotating them with clinical information, I detected patterns in the patients' expression profiles across 18,351 genes that correspond to luminal and triple negative breast cancers.
I discovered biological processes that distinguish cancer cell lines based on the aggressiveness of the cancers they model. For both breast cancer and colon cancer cell lines, I calculated, visualized, and functionally annotated differential gene expression profiles with data from the Physical Sciences in Oncology Cell Line Characterization Study.
I built linear regression models that are predictive of breast cancer survival from the METABRIC breast cancer dataset. I found that gene expression profiles of certain cancer genes are predictive of prognosis. Inclusion of additional features in my model increased its explanatory power.